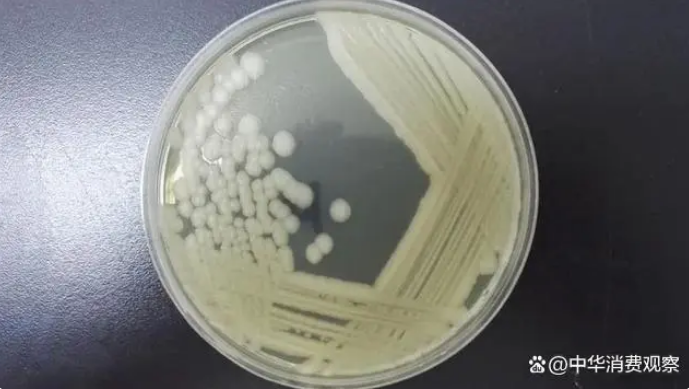

来源:优选消费者报告

夏天到了 ,食品的储存成了大问题,稍有一不慎,就存在安全隐患。
近日,中国知名品牌“王致和”豆腐乳被欧盟要求召回。

根据马尔他以及比利时食品监管部门的报告显示,这批次“王致和”豆腐乳可能存在蜡样苞芽杆菌,所以要求生产者召回。
蜡样苞芽杆菌又称为仙人掌杆菌,因周身布满短鞭毛,形如仙人掌因而得名。在环境中分布广泛,可由细菌本身或由细菌产生之毒素而导致食品中毒,引起之中毒症状可分为呕吐型及腹泻型两类。

无独有偶,就在欧盟召回“王致和”时,香港也在召回另一个品牌的豆腐乳。
6月11日,香港食品安全中心发出公告,其在常规食物抽检中,在荃湾一个零售点对一款名为“悦和酱园”的豆腐乳进行检测时,发现该样本每克含十三万个蜡样芽孢杆菌。根据《食品微生物含量指引》,即食食品每克含超过十万个蜡样芽孢杆菌即属不合格产品。
于是香港食安中心一方面警告全港市民不要购买此品牌腐乳,同时要求厂家立即召回。

为什么这种细菌喜欢在豆腐乳上做妖呢?
这是由三方面所造成的。
首先,是原材料自身的影响。
在大豆种植过程中,土壤中的微生物有可能是引起豆制品变质的腐败菌来源之一。这些土壤中的微生物在大豆种植期间会受到相关因素的影响,比如发育期、降水量以及轮作的影响等。
第二,是受生产过程的影响。
我国豆制品厂用的大豆原料都是从地里收割、一般没有经过任何特殊处理便投入生产,会沾有泥土、粪便等污染物,因此残留着大量的微生物
因为担心过热会使豆浆黏度增加, 不利于与凝固剂混合,影响其硬度。所以,在豆制品的加工过程中, 一般采用较为温和的加热煮浆方式, 这样革兰氏阳性芽孢杆菌和耐热菌会残留下。
而且豆腐加工过程中,需要加入内酯、石膏、盐卤等凝固剂,极易在生产中将杂菌引入。
第三,对于普通消费者而来,更容易犯的错误是贮藏不当。
例如,有一种名为“炒饭综合征”的病,也与蜡样芽孢杆菌脱不开关系。这种上吐下泻的病症,通常在室温下长时间放置的炒饭或米饭中被发现,故由其引起的病症也称为“炒饭综合征”。
其根源就是剩饭储藏不当,沾染上了仙人掌杆菌。

所以,炎炎夏日,我们还是要牢记下面这个生活小常识,远离仙人掌杆菌:
保持食物的安全温度。
熟食不宜室温下放置过久(建议不超过2小时)。如不立即食用,应尽快冷却,低温保存,所有熟食和易腐烂的食物应及时冷藏(建议5℃以下)。再次食用前应充分加热(60℃以上)。即便在冰箱中也不能过久储存食物。冷冻食物不宜在室温下解冻,可采用微波炉解冻、冰箱冷藏室解冻等。
研究数据显示,保持热食(高于60℃)和冷食(低于4℃)能有效降低感染蜡样芽孢杆菌疾病的风险。

祝您度过一个健康的夏日!
如果您有想了解的国内外产品质量测评,欢迎留言给我们。
 微信扫一扫打赏
微信扫一扫打赏
 支付宝扫一扫打赏
支付宝扫一扫打赏




